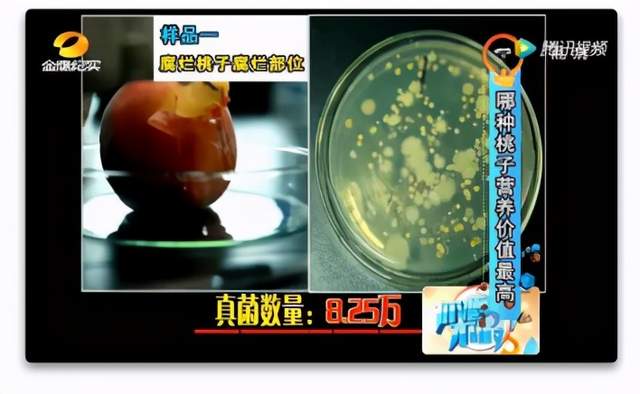
水果|58岁男子因吃烂水果住进ICU,你的节俭正在毁掉你的健康

水果|58岁男子因吃烂水果住进ICU,你的节俭正在毁掉你的健康

文章图片

文章图片
文章图片

文章图片

文章图片

文章图片
现在越来越多的人 , 因平时工作繁忙 , 很少有时间去光顾水果店、菜市场 , 一个个都成了爱囤粮食的“小仓鼠” 。
每次一逮到休息的时间 , 水果、蔬菜、各种吃吃喝喝的 , 管他三七二十一 , 一次性买个够 , 直接塞满冰箱 。
然而 , 水果、蔬菜时间一但放久了 , 亦或是保存不当 , 就会不知不觉中变坏~
问题来了!它们才坏了一点 , 还能不能吃呢?
很多人内心OS都是:想扔掉又舍不得 , 毕竟花自己血汗钱买的 , 将坏掉的部分剜掉 , 然后吃“好”的那一部分就行了 。
可你们不知道的是 , 这“节约美德”的背后 , 也隐藏着某种可怕的风险 。
一、只坏掉一点的水果 , 不能吃?都说坏一点的水果吃不得 , 但继承了勤俭节约美德的朋友们 , 未必真听的进去!
不过 , 小编还是想提醒你们 , 坏掉的水果真的不要吃 , 轻则生病 , 重则可能丧命!
中国预防医学科学院的有一项调查发现 , 在一颗少许霉变苹果中 , 外观正常的部分也含有展青霉素 , 且通常占霉变部位的10%-50% 。
也就是说 , 当我们可以看到水果变坏的部分时 , 就说明它已经是不能吃的了 , 那些肉眼看不到的其他部分 , 也已经有霉菌的存在 , 你若执意要吃 , 极大可能会危害你的身体健康!
别怀疑!南方健康曾报道过这样一则新闻:58岁老人剜去腐烂的果肉吃完之后 , 导致全身水肿 , 直接住进ICU 。
那么 , 问题来了 , 果蔬一旦变坏 , 危害到底有多大?赶紧跟着小编来一探究竟吧~
1、背的凶手 , 竟然是“它”
其实 , 害人的不是水果本身 , 而是水果变坏后 , 产生的“展青霉素”在作祟 , 它属于有害霉菌 , 主要依附于水果才得以生存 。
等等!好端端的水果 , 怎么会有展青霉素呢?
这是因为空气中本身就存在很多微生物 , 而每一个新鲜的水果表面 , 也都围绕着一群饥渴的微生物 。
其中最常见的就是真菌 , 它在一定的温度和湿度条件下(ps:如潮湿、阴暗、不通风等) , 一旦接触到水果的表面 , 它就会立马渗透到水果的内部 , 跟水果的汁液攀上关系后 , 就升级出了展青霉素 。
展青霉素的威力不容小觑 , 它能深入渗透到水果腐烂部位附近2厘米左右的健康组织中 , 也就是说 , 你看起来没坏的那部分 , 跟坏的那部分 , 区别不大 , 都已经被污染了 。
一般来说 , 一旦发现水果出现霉菌现象 , 等2~3天后就能看到菌了 , 一星期后细菌孢子就会开始向四周散开 , 就开始了“果传果”现象 。
这就是为什么摆放在一起的水果 , 只要其中一个坏了 , 周围的水果也会跟着变坏的原因所在了 。
2变坏后的水果 , 居然这么可怕?
湖南电视台 , 金鹰纪实频道曾做过这样一档科普栏目 。
- 水果|过年水果选哪些?这些优质年货,在你的购物清单上吗?
- 苹果|冬季最应该吃的水果,苹果和梨都不如它,4元1斤,多给老人孩子吃
- 警惕夏季水果病
- 水果该怎么健康去吃 专家为您解答
- 吃生姜加苹果,一个调料一个水果,连续吃一个月
- 水果|冰箱里放这3种食物,拿出来就得扔掉,吃了会损坏健康?
- 口腔溃疡不用怕 多吃水果
- 高血压|花生是高血压恶化的“助推器”?医生提醒:1种水果要忌口,以免心梗“上门”
- 春季吃什么水果好 补充维生素为原则
- 小林|男子一晚呼吸暂停176次?睡觉打鼾并非好事,背后或与这3件事有关
